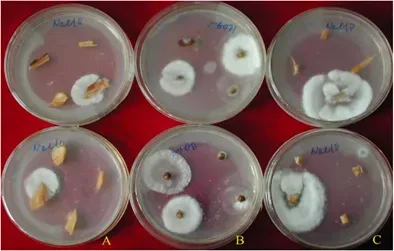
Endófitos Petri

· Felipe Vengoechea · trabajo-de-laboratorio
Endófitos: avances en ingeniería genética y biorremediación
¿Qué son los hongos endófitos? Organismos que viven dentro de las plantas, mejorando su resistencia y salud sin causar daño.

¿Qué son los endófitos?
Los hongos endófitos son una categoría fascinante de microorganismos que viven dentro de las plantas sin causarles daño aparente. Estos hongos, cuyo nombre proviene del griego “endo”, que significa “dentro”, y “fito”, que significa “planta”, han evolucionado para existir en simbiosis con sus anfitriones vegetales, a menudo proporcionando beneficios significativos a la planta.
¿Dónde se encuentran los hongos endófitos?
Los hongos endofíticos se encuentran habitualmente en las plantas, y su presencia y función han estado durante mucho tiempo sin descubrir porque viven en el interior de los tejidos sanos de las plantas sin presentar síntomas externos de infección.

Importancia de los hongos endófitos
La importancia de los hongos endófitos no puede ser subestimada. Estos microorganismos juegan un papel crucial en la salud y supervivencia de las plantas, contribuyendo a su resistencia a enfermedades, tolerancia al estrés y capacidad para adaptarse a diferentes condiciones ambientales. Además, los hongos endófitos también tienen un potencial considerable en la biotecnología, la medicina y la agricultura, lo que los convierte en un área de investigación científica de gran interés.
Clasificación de los hongos endófitos
Según su ubicación en la planta
Los hongos endófitos pueden clasificarse según la parte de la planta en la que residen. Algunos hongos endófitos, conocidos como endófitos foliares, viven en las hojas de las plantas. Otros, como los endófitos radiculares, se encuentran en las raíces. También hay hongos endófitos que pueden colonizar los tallos, las semillas y otras partes de la planta.
Según su interacción con la planta
Otra forma de clasificar a los hongos endófitos es según la naturaleza de su interacción con la planta anfitriona. Algunos hongos endófitos son mutualistas, lo que significa que tanto la planta como el hongo se benefician de la relación. Otros son comensales, lo que significa que el hongo se beneficia de la planta sin causarle daño. En algunos casos, los hongos endófitos pueden convertirse en patógenos bajo ciertas condiciones, causando enfermedad en la planta.
biología y ecología de los hongos endófitos
Ciclo de vida
El ciclo de vida de los hongos endófitos es un tema de gran interés para los científicos. Estos hongos pueden transmitirse de una planta a otra a través de esporas, que son dispersadas por el viento, el agua o los animales. Una vez que las esporas llegan a una planta susceptible, germinan y el hongo comienza a colonizar el tejido de la planta.
Modos de transmisión
Los hongos endófitos pueden transmitirse de dos maneras principales: de manera horizontal y vertical. La transmisión horizontal ocurre cuando las esporas del hongo son dispersadas al ambiente y colonizan nuevas plantas. La transmisión vertical, por otro lado, ocurre cuando el hongo se transmite de una generación de plantas a la siguiente a través de las semillas. Ambos modos de transmisión son esenciales para la supervivencia y propagación de los hongos endófitos.
Interacciones con otros organismos
Los hongos endófitos no existen en aislamiento. Interactúan con una variedad de otros organismos en su entorno, incluyendo otras especies de hongos, bacterias, insectos y animales. Estas interacciones pueden ser competitivas, con los hongos endófitos luchando por recursos con otros microorganismos, o pueden ser mutualistas, con los hongos endófitos formando asociaciones beneficiosas con otros organismos.
Beneficios de los hongos endófitos
Mejora de la resistencia a las enfermedades
Uno de los beneficios más notables de los hongos endófitos es su capacidad para mejorar la resistencia de las plantas a las enfermedades. Algunos hongos endófitos producen compuestos antimicrobianos que pueden inhibir el crecimiento de patógenos de las plantas. Otros pueden inducir la respuesta inmune de la planta, ayudándola a defenderse contra los patógenos.
Mejora de la tolerancia al estrés abiótico
Los hongos endófitos también pueden ayudar a las plantas a tolerar el estrés abiótico, como la sequía, la salinidad, las altas temperaturas y la contaminación del suelo. Algunos hongos endófitos pueden mejorar la absorción de agua y nutrientes de la planta, ayudándola a sobrevivir en condiciones de sequía. Otros pueden producir compuestos que protegen a la planta del daño causado por el estrés salino o térmico.
Promoción del crecimiento de las plantas
Además de mejorar la resistencia a las enfermedades y la tolerancia al estrés, los hongos endófitos también pueden promover el crecimiento de las plantas. Algunos hongos endófitos pueden producir hormonas de crecimiento vegetal o ayudar a la planta a absorber nutrientes esenciales del suelo, lo que resulta en un crecimiento más rápido y un mayor rendimiento.
Aplicaciones de los hongos endófitos
En agricultura
Los hongos endófitos tienen un potencial considerable en la agricultura. Pueden utilizarse como biofertilizantes, mejorando la absorción de nutrientes de las plantas y promoviendo su crecimiento. También pueden utilizarse como biopesticidas, protegiendo a las plantas contra una variedad de patógenos y plagas. Además, los hongos endófitos pueden mejorar la tolerancia de las plantas al estrés abiótico, lo que es especialmente importante en la era del cambio climático.
Hongos endofíticos
Los hongos endófitos de plantas se estudian principalmente en plantas medicinales, plantas de festuca y árboles tropicales.
Los hongos endofíticos encontrados son sobre todo ascomycetes y sus formas asexuales, incluyendo Pyrenomycetes, Discomycetes y Loculoascomycetes.
Actinomicetos endofíticos
Los actinomicetos endofíticos de las plantas se estudian principalmente en los manglares, los árboles tropicales perennes y algunos cultivos medicinales, principalmente Streptomyces, Streptoverticillum, Actinoplanes, Nocardia, Micromonospora.
Producción agrícola con endófitos
La investigación ha demostrado que los endófitos de las plantas comparten el mismo nicho ecológico que los patógenos y compiten entre sí por el espacio y los nutrientes en la planta, de modo que los patógenos se ven privados del suministro normal de nutrientes y mueren, lo que aumenta la capacidad del huésped para resistir la enfermedad. Además, las bacterias endofíticas pueden segregar sustancias metabólicas, como antibióticos y toxinas, que pueden inducir una resistencia sistémica (ISR) en las plantas. Por lo tanto, la aplicación de agentes antimicrobianos y antiinsecticidas producidos por los endófitos de las plantas para mejorar su resistencia y proporcionar efectos de control biológico.
Esto tiene efectos positivos al limpiar el medio ambiente de pesticidas y abonos quimicos, mejora el rendimiento de las plantas y existen pruebas sobre sus propiedades repelentes contra polillas.
Propiedades medicinales de los endófitos
Los hongos endófitos también tienen aplicaciones prometedoras en el campo de la medicina. Algunos hongos endófitos producen compuestos bioactivos que tienen propiedades antimicrobianas, anticancerígenas, antiinflamatorias y antioxidantes. Estos compuestos podrían ser utilizados para desarrollar nuevos medicamentos para tratar una variedad de enfermedades. Además, los hongos endófitos también podrían ser utilizados en la producción de probióticos para mejorar la salud intestinal.
Las investigaciones han demostrado que los metabolitos de los hongos endofíticos de las plantas tienen efectos antitumorales, antibacterianos y antivirales. Gary y Strobel et al. aislaron el hongo endofítico Acremzonium sp. de la caña roja europea, que puede producir una serie de sustancias activas péptidas antifúngicas y anticancerígenas, entre las cuales la leucinostatina puede inhibir muy bien algunas células tumorales humanas.
El hongo endofítico Cryposporiopsis cf. quercina, aislado por el grupo de Strobel a partir de la conocida planta medicinal Leucinostatin de la familia Weigela, produce un nuevo antibiótico péptido cíclico, la criptocandina, que tiene un fuerte efecto inhibidor sobre los hongos patógenos humanos como la tiña y la Candida albicans, con una CMI comparable a la del fármaco antifúngico de uso clínico anfotericina B. Castillo et al. descubrieron que una cepa endofítica de Streptomyces nzgriscans era capaz de producir una clase de péptidos activos, las Munumbicicinas, que no sólo tenían una actividad antibacteriana de amplio espectro, sino que también tenían buenos efectos inhibidores sobre los patógenos y parásitos resistentes a los medicamentos.
El uso de los metabolitos secundarios de las bacterias endofíticas para desarrollar nuevos fármacos será una de las futuras líneas de investigación en medicina.

Hongos Endófitos: Ingenieros Genéticos Naturales
Los Endófitos como Vehículos de Genes Exógenos
Los hongos endófitos, gracias a su capacidad para adaptarse a las plantas, han sido objeto de interés para los investigadores en el campo de la ingeniería genética. Algunos científicos han modificado bacterias endófitas para que actúen como portadoras de genes de resistencia a enfermedades o insecticidas, y luego las han introducido en las plantas. De esta manera, las plantas pueden funcionar como plantas transgénicas resistentes a enfermedades e insectos, lo que contribuye al control biológico de plagas y enfermedades.
Casos de Estudio en la Ingeniería genética con Endófitos
En el año 2000, Dowring y su equipo llevaron a cabo un estudio en el que transfirieron un gen de resistencia a enfermedades al hongo endófito Pseudomonesa fluorescens, aislado de plántulas de manzana. Posteriormente, este hongo endófito portador del gen fue inoculado en plántulas de judías para controlar el hongo patógeno Rhizoctomia solani. En un experimento similar, transfirieron el gen de resistencia a insectos cry 1AC7 al hongo endófito de la caña de azúcar, que luego fue reintroducido en la caña de azúcar para controlar el gusano del corazón de la caña de azúcar, Eldana saccharina.
Aplicaciones de la Ingeniería genética con Endófitos en Agricultura
En otro estudio, la bacteria endofítica Clavibacter xyli subsp. cyndontis se utilizó como vector para integrar el gen del insecticida BT en el cromosoma, creando así una bacteria de ingeniería de insecticidas. Esta bacteria modificada genéticamente se probó en grandes ensayos de campo en 12 híbridos de maíz en cuatro estados de EE.UU. desde 1988 y se encontró que podía reducir la tasa de daños por insectos entre un 26% y un 72%.
Endófitos en la Biorremediación Ambiental
Los hongos endófitos también han demostrado tener un gran potencial en la biorremediación ambiental. Por ejemplo, se ha descubierto que las bacterias endofíticas aisladas de los manglares del estuario del río Pearl tienen la capacidad de eliminar sustancias nocivas de las aguas residuales industriales y purificar el agua de mar. Además, Barac y su equipo demostraron que ciertas bacterias endofíticas pueden degradar el tolueno y hacer que sus plantas huésped sean resistentes al tolueno. Esto abre la posibilidad de utilizar microorganismos para inocular plantas para la remediación ambiental. Aunque la investigación en este campo está en sus primeras etapas, los hongos endófitos representan una nueva y prometedora herramienta para el control de la contaminación ambiental.
En biotecnología
La biotecnología es otro campo en el que los hongos endófitos tienen un potencial considerable. Los hongos endófitos pueden ser utilizados en la producción de enzimas industriales, biofertilizantes, biopesticidas y otros productos biotecnológicos. Además, los hongos endófitos también podrían ser utilizados en la biorremediación, un proceso que utiliza organismos vivos para descontaminar el suelo y el agua.
Estudios de caso
Ejemplos de hongos endófitos y sus aplicaciones
Existen numerosos ejemplos de hongos endófitos y sus aplicaciones en la agricultura, la medicina y la biotecnología. Por ejemplo, el hongo endófito Epichloë festucae ha sido utilizado para mejorar la resistencia de las plantas de pasto a las plagas y las enfermedades. Otro hongo endófito, Penicillium citrinum, ha sido utilizado para producir citrinina, un compuesto con propiedades antimicrobianas y anticancerígenas. Además, el hongo endófito Phoma sp. ha sido utilizado en la biorremediación de suelos contaminados con metales pesados.
Desafíos y perspectivas futuras
Desafíos en la investigación y aplicación de hongos endófitos
A pesar de su potencial, la investigación y aplicación de hongos endófitos también enfrenta varios desafíos. Uno de los principales desafíos es la dificultad de cultivar hongos endófitos en el laboratorio, lo que limita la capacidad de los científicos para estudiar estos organismos y aprovechar su potencial. Otro desafío es la variabilidad en la interacción entre los hongos endófitos y las plantas, lo que puede dificultar la predicción de los efectos de los hongos endófitos en las plantas.
Perspectivas futuras
A pesar de estos desafíos, las perspectivas futuras para la investigación y aplicación de hongos endófitos son prometedoras. Con los avances en la tecnología de secuenciación de ADN, los científicos ahora tienen la capacidad de estudiar los hongos endófitos a nivel genómico, lo que podría proporcionar nuevas ideas sobre la biología y ecología de estos organismos. Además, con el creciente interés en la agricultura sostenible, la medicina natural y la biotecnología verde, es probable que la demanda de hongos endófitos y sus productos continúe aumentando.
Los hongos endófitos son una clase de microorganismos fascinantes que viven en simbiosis con las plantas. Aunque a menudo pasan desapercibidos, estos hongos juegan un papel crucial en la salud y supervivencia de las plantas, y tienen un potencial considerable en la agricultura, la medicina y la biotecnología. A pesar de los desafíos, las perspectivas futuras para la investigación y aplicación de hongos endófitos son prometedoras. Con los avances en la tecnología y un creciente interés en la sostenibilidad, es probable que veamos un aumento en la utilización de hongos endófitos en los años venideros.
Endófitos en Laboratorio
Métodos de aislamiento de hongos endófitos
El aislamiento de hongos endófitos es un proceso meticuloso que requiere precisión y cuidado. El primer paso es la recolección de muestras de plantas, que puede incluir hojas, tallos, raíces o semillas, dependiendo de la ubicación del hongo endófito de interés.
Una vez recolectadas, las muestras se someten a un proceso de esterilización de superficie para eliminar los microorganismos que residen en el exterior de la planta. Este proceso generalmente implica el uso de agentes esterilizantes como el alcohol y el hipoclorito de sodio. Es importante asegurarse de que la esterilización de la superficie sea efectiva, ya que los microorganismos de la superficie pueden contaminar las culturas y dificultar el aislamiento de los hongos endófitos.
Después de la esterilización, las muestras se cortan en pequeños fragmentos y se colocan en un medio de cultivo adecuado. Los medios de cultivo contienen nutrientes que promueven el crecimiento de los hongos. Las muestras se incuban a una temperatura adecuada y se observan regularmente para detectar el crecimiento de los hongos.
técnicas de estudio de hongos endófitos
El estudio de los hongos endófitos implica una variedad de técnicas, dependiendo del objetivo de la investigación.
La microscopía es una técnica fundamental que permite a los investigadores observar los hongos endófitos en el tejido de la planta. Esto puede proporcionar información valiosa sobre la ubicación y la morfología de los hongos.
La cultura de tejidos es otra técnica importante que permite a los investigadores cultivar hongos endófitos en el laboratorio. Esto permite el estudio detallado de los hongos, incluyendo su morfología, fisiología y genética.
La secuenciación de ADN es una técnica poderosa que permite a los investigadores identificar y caracterizar hongos endófitos a nivel genómico. Esto puede proporcionar información sobre la taxonomía de los hongos, así como sobre los genes que pueden estar involucrados en la interacción con la planta anfitriona.
Tendencias actuales en la investigación de hongos endófitos
La investigación de los hongos endófitos es un campo dinámico con muchas tendencias emergentes. Una de estas tendencias es el estudio de la diversidad y ecología de los hongos endófitos. Los investigadores están utilizando técnicas de secuenciación de ADN para explorar la diversidad de hongos endófitos en diferentes plantas y ecosistemas.
Otra tendencia es la elucidación de los mecanismos de interacción entre los hongos endófitos y las plantas. Esto incluye el estudio de cómo los hongos endófitos pueden mejorar la resistencia de las plantas a las enfermedades y el estrés abiótico, así como cómo pueden promover el crecimiento de las plantas.
Finalmente, una tendencia importante es la exploración de las aplicaciones de los hongos endófitos en la agricultura, la medicina y la biotecnología. Los investigadores están buscando formas de aprovechar los beneficios de los hongos endófitos para mejorar la producción de cultivos, desarrollar nuevos medicamentos y producir productos biotecnológicos.
En el contexto del cambio climático, también hay un creciente interés en el estudio de cómo los hongos endófitos pueden ayudar a las plantas a adaptarse a las condiciones de estrés abiótico, como la sequía y la salinidad. Además, los hongos endófitos también están siendo estudiados por su potencial en la biorremediación, un proceso que utiliza organismos vivos para descontaminar el suelo y el agua.
La investigación de los hongos endófitos es un campo emocionante y en rápido desarrollo con muchas posibilidades para nuevas descubrimientos y aplicaciones.
Referencias
- Rodriguez, R.J., White, J.F., Arnold, A.E., Redman, R.S. (2009). Fungal endophytes: diversity and functional roles. New Phytologist, 182(2), 314-330.
- Saikkonen, K., Faeth, S.H., Helander, M., Sullivan, T.J. (1998). Fungal endophytes: a continuum of interactions with host plants. Annual Review of Ecology and Systematics, 29, 319-343.
- Schulz, B., Boyle, C. (2005). The endophytic continuum. Mycological Research, 109(6), 661-686.
- Strobel, G., Daisy, B. (2003). Bioprospecting for microbial endophytes and their natural products. Microbiology and Molecular Biology Reviews, 67(4), 491-502.
- Tan, R.X., Zou, W.X. (2001). Endophytes: a rich source of functional metabolites. Natural Product Reports, 18(4), 448-459.
- Aguilar, J. (2013). Hongos de Espa¡a y de Europa. Ediciones Omega.
- Garc¡a Roll¡n, M. ¡. (2011). Hongos: Guía de campo. RBA Libros.
- Garc¡a Roll¡n, M. ¡. (2013). Hongos: Atlas Ilustrado. RBA Libros.
- L¡ssíe, T., & Petersen, J. H. (2019). Guía de los hongos de Europa. Omega.
- Caujap¡-Castells, J., & Gavald¡-Miralles, J. (2012). Los Hongos y su Importancia para la Vida. Ediciones Jaguar.
- Salazar Allen, G. (2005). micología básica. Universidad Nacional Aut¡noma de M¡xico.
- Arenas Roberto. (2008). Micología Médica Ilustrada. McGraw-Hill Interamericana.
- Mendiola Llorente, M. I., & Tellería Orriols, M. T. (2008). Micología Experimental. Universidad de Cantabria.
- García Fernández, M. C. (2009). Micología y Toxicología. Ediciones Díaz de Santos.
- Kirk, P. M., & Cannon, P. F. (2001). Micología: El Estudio de los Hongos. Acribia.
- Gerhardt, E. (2018). Pilze in Farben. Kosmos Verlag.
- Krieglsteiner, L. (2011). Morcheln: Pilze der Familie Morchellaceae. Verlag Josef Margraf.
- Breitenbach, J., & Kränzlin, F. (1995). Die Welt der Pilze: Eine Übersicht über die Pilze Mitteleuropas. Verlag Eugen Ulmer.
- Laux, H. E. (2018). Der große Pilzführer: Die bekanntesten Arten Mitteleuropas.


